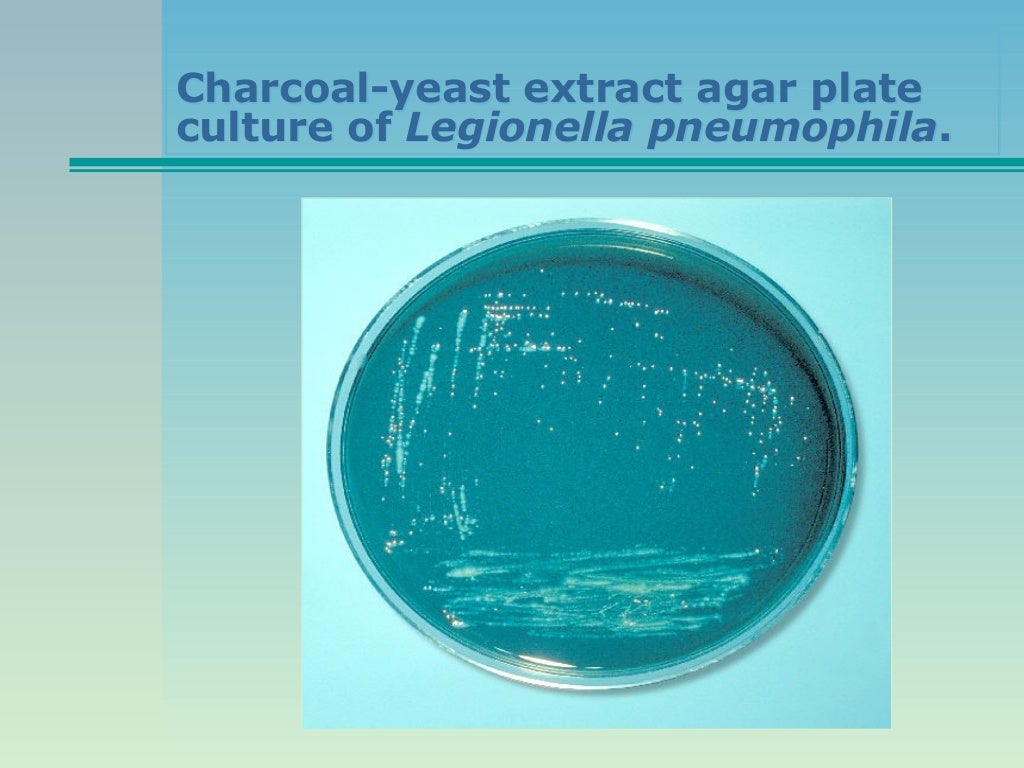

The extract of yeast is a rich source of both vitamins nitrogen and carbon. Aseptically add sterile rehydrated contents of 1 vial each of legionella supplement.
Buffered Charcoal Yeast Extract Agar Base Microbiology
Legionella Bordetella And Haemophilus

How To Culture On Buffered Charcoal Yeast Extract Agar
Hardy diagnostics buffered charcoal yeast extract bcye agar formulations are recommended for use in the cultivation and primary isolation of legionella spp.

Buffered charcoal yeast. The media contains charcoal a detoxifier. We enable science by offering product choice services process excellence and our people make it happen. In water and other samples suspected of harboring the bacteria.
Sterilize by autoclaving at 15 lbs pressure 1210c for 15 minutes. 38 although uncommon n. Aces buffer maintains optimum ph for growth while l cysteine hydrochloride stimulates the growth of legionella species with ferric pyrophosphate and a ketoglutarate.
Buffered charcoal yeast extract selective agar with cephalothin colistin vancomycin and cycloheximide for the selective isolation and cultivation of legionella from environmental and clinical specimens. Suspend 20 grams in 500 ml distilled water. Buffered charcoal yeast extract agar base m813 buffered charcoal yeast extract agar base with added supplements is used for selective cultivation of legionella species from clinical and other specimens.
Heat to boiling to dissolve the medium completely. Asteroides complex strains can be isolated in automated blood culture systems especially if patients are receiving immunosuppressive therapy. Pretreatment with an acid wash and inoculation onto selective buffered charcoal yeast extract agar as formulated for the detection of legionella spp can increase the recovery of nocardia from respiratory specimens.
Buffered charcoal yeast extract bcye agar is a selective growth medium used to culture or grow certain types of bacteria particularly the gram negative species legionella pneumophila. Principle of buffered charcoal yeast extract agar. Mix well and pour with constant.
Learn more about bcye agar buffered charcoal yeast extract hardy diagnostics. Buffered charcoal yeast extract bcye feeley et al in 1978 developed a medium to isolate legionella species which was later modified by substituting yeast extract for casein hydrolysate and beef extract and replacing starch with activated charcoal and named it as charcoal yeast extract cye agar. 1 it has also been used for the laboratory diagnosis of acanthamoeba keratitis 2 francisella and nocardia.

Bcye Without L Cysteine Agar
Buffered Charcoal Yeast Extract Agar
Lecture 24 Legionella

EmoticonEmoticon